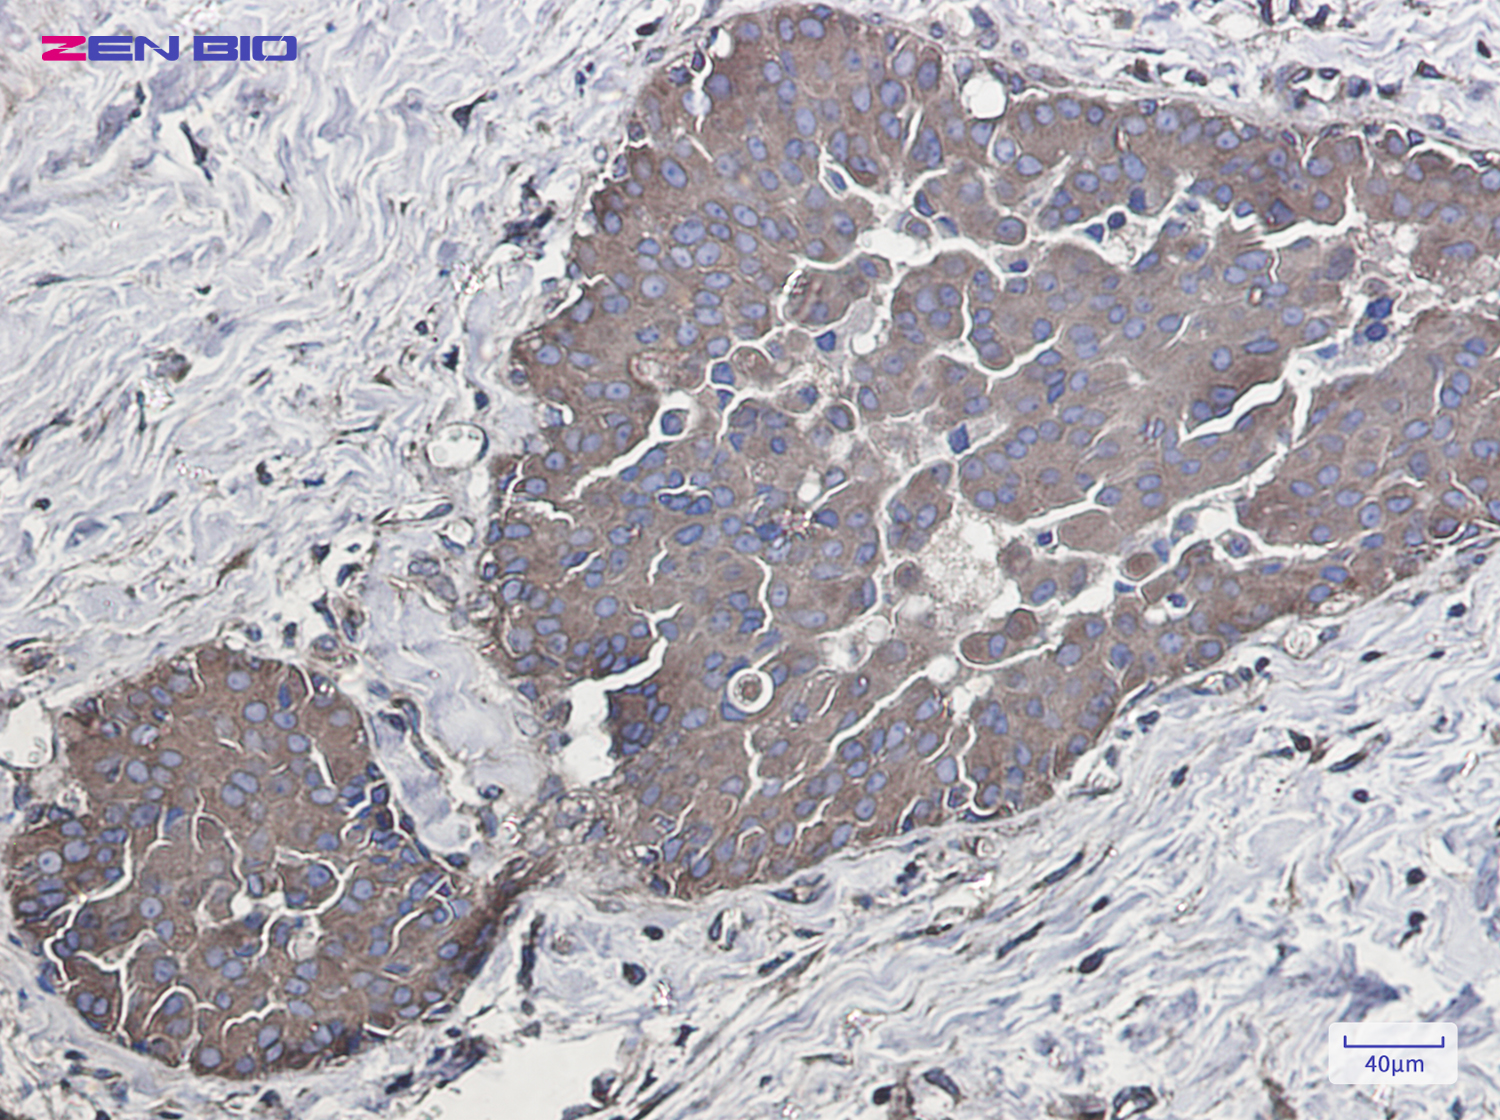
Immunohistochemistry of Rab5 in paraffin-embedded Human breast cancer tissue using Rab5 Rabbit pAb at dilution 1/50

-
Product Name
Anti-Rab5 Rabbit antibody
- Documents
-
Description
Rab5 Rabbit polyclonal antibody
-
Tested applications
WB, IHC-P, ICC/IF, FC, IP
-
Species reactivity
Human, Mouse, Rat
-
Alternative names
RAB5 antibody
-
Isotype
Rabbit IgG
-
Preparation
Antigen: A synthetic peptide of human Rab5
-
Clonality
Polyclonal
-
Formulation
Supplied in 50nM Tris-Glycine(pH 7.4), 0.15M Nacl, 40%Glycerol, 0.01% sodium azide and 0.05% BSA.
-
Storage instructions
Store at -20°C. Stable for 12 months from date of receipt.
-
Applications
WB: 1/1000
IHC: 1/500
ICC/IF: 1/200
FC: 1/20
IP: 1/20
-
Validations
Immunohistochemistry of Rab5 in paraffin-embedded Human breast cancer tissue using Rab5 Rabbit pAb at dilution 1/50

Western blot detection of Rab5 in K562,C6,3T3,Hela cell lysates using Rab5 Rabbit pAb(1:1000 diluted).Predicted band size:24kDa.Observed band size:24kDa.
-
Background
Swiss-Prot Acc.P20339.The small GTPases Rab are key regulators of intracellular membrane trafficking, from the formation of transport vesicles to their fusion with membranes. Rabs cycle between an inactive GDP-bound form and an active GTP-bound form that is able to recruit to membranes different sets of downstream effectors directly responsible for vesicle formation, movement, tethering and fusion. RAB5A is required for the fusion of plasma membranes and early endosomes (PubMed:10818110, PubMed:14617813, PubMed:16410077, PubMed:15378032). Contributes to the regulation of filopodia extension (PubMed:14978216). Required for the exosomal release of SDCBP, CD63, PDCD6IP and syndecan (PubMed:22660413). Regulates maturation of apoptotic cell-containing phagosomes, probably downstream of DYN2 and PIK3C3 .
Related Products / Services
Please note: All products are "FOR RESEARCH USE ONLY AND ARE NOT INTENDED FOR DIAGNOSTIC OR THERAPEUTIC USE"
